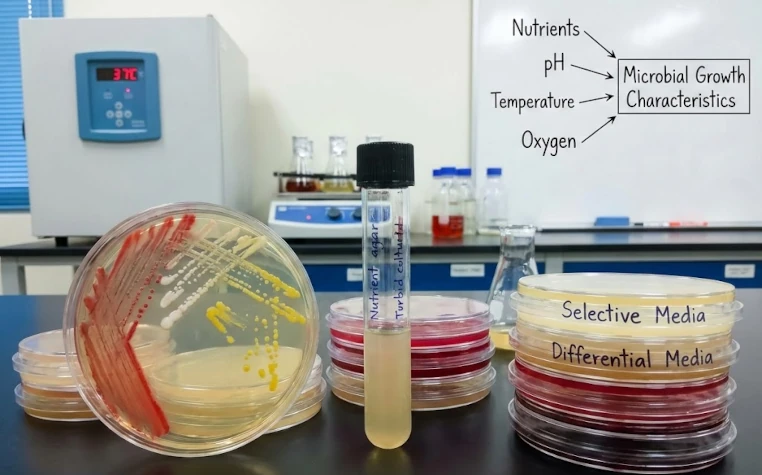
Wachstumsmedien von Mikroorganismen und Wachstumseigenschaften

Die Biostatistik und ihre Verwendung in den Gesundheitswissenschaften
Die Biostatistik ist ein unverzichtbares Instrument in den Gesundheitswissenschaften. Sie ermöglicht die Analyse von Daten und unterstützt die evidenzbasierte Praxis in der Medizin. ddo-